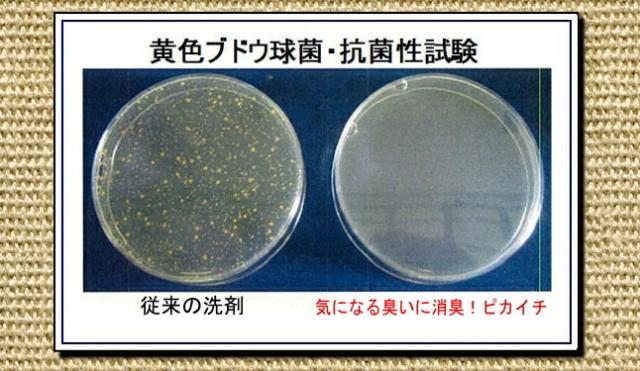

【お得クーポン配布中】ノロ・インフルエンザ猛威!ウィルス対策◎メール便にて送料無料☆無リン 衣類の消臭・除菌の衛生洗剤「気になる臭いに消臭!ピカイチ」 350g35回分
1,430円(税込)
0ポイント(1%)
配送情報
お届け予定日:2月24日〜2月28日
※一部地域・離島につきましては、表示のお届け予定日期間内にお届けできない場合があります。ロットナンバー
734012612
商品説明
製造地:静岡県浜松市
| 350g入り パッケージをリニューアルして お求めやすくなりました。 大幅値下げ 従来価格2,100円⇒新価格1,365円 メール便発送のため、代引き決済不可となります。 |
モニター様、大絶賛!
加齢臭・汗の臭い・ワキガなどの体臭をスッキリ消臭
強力除菌で、ニオイの元となる雑菌もシャットアウト
消臭・除菌洗剤
「気になる臭いに消臭!ピカイチ」
![]() |
| 加齢臭・汗の臭い体臭が気になる方に朗報 洗濯で悪臭を落とす洗剤 |
![]() |
| 芳香剤の香り |
![]() |
| お年寄りの臭い感染対策 衣類・シーツのお洗濯 老人施設で活躍 |
| ◎洗剤で消臭・除菌…その仕組みとは? |
| 「気になる臭いに消臭!ピカイチ」には過酢酸という除菌剤が配合されています。 過酢酸は、広範囲の高い除菌効果・即効性・無害性・非危険物という特性を持っており、現在、最も注目されている除菌剤です。 過酢酸から発生する活性酸素が強力な除菌効果を発揮します。 過酢酸は多方面で殺菌消毒薬として使用され、主に医療器具の滅菌・殺菌・消毒に用いられています。 しかも、成分は実質的に無害ということで、人にはもちろんかわいいペットにも安心してご利用していただけます。 また、臭いのほとんどが菌に由来するという事実から、過酢酸には除菌と同時に強力な消臭効果も発揮します。 |
![]() |
| 黄色ブドウ球菌・抗菌性試験 加齢臭!ピカイチ |
| ◎真の衛生とは…? |
| 真っ白なハンカチ・ふきん・ワイシャツ…。 すくなくとも洗濯においては、これまでは、汚れさえきれいに洗い落としていれば清潔感があり衛生的であるといういうのが一般的な感覚でありました。 ところが、日本人の清潔・安全志向に加え、MRSAによる院内感染や病原性大腸菌O157等による集団食中毒事件等をきっかけとして、近年、衛生に対する観念が急激に変化いたしました。 洗濯においても、汚れ落としだけでなく、除菌・消臭の効果を備えた「衛生洗剤」へのニーズが高まっているのが実情です。 ペット用品を消臭・除菌する衛生洗剤もあります。「ペットの消臭・除菌!ピカイチ」はこちら… |
| 気になる臭いに消臭!ピカイチ 商品詳細 | |
|---|---|
| 商品名 | 気になる臭いに消臭!ピカイチ |
| 液性 | 弱アルカリ・無リン |
| パッケージ | お手軽パック 350g お手軽パック 350g×2個セット お徳用 1.2kg お徳用 1.2kg×3個セット お徳用 1.2kg×6個セット お徳用 1.2kg×10個セット お試しセット 50g |
| 成分 | 界面活性剤(11% ポリオキシアルキレンアルキルエーテル) 純石鹸分(脂肪酸ナトリウム) アルカリ剤(炭酸塩) 水軟化剤 工程剤 酵素 過酢酸 蛍光増白剤 酸素系漂白剤 |
| 使用量の目安と 使用方法 |
通常の洗濯機での洗濯(水位30ℓに対して10?15g)でも十分に機能を発揮しますが、浸け置きいたしますとさらに効果的です。 5ℓのお湯(40℃から50℃)に対し本製品10?15g (※付属計量スプーン10cc 2杯で15g)をよく溶かして、1時間浸け置きします。 浸け置き時間が長いほど効果的ですが、1時間以内で十分です。 また、臭い・汚れがひどい場合は浸け置き後にかるくもみ洗いするとさらに効果的です。 漬け置き後は、漬け置きの溶液と一緒に通常通りの洗濯機でのお洗濯をしてください。 この際、水位30ℓ以内の洗濯物量であれば、洗剤の追加は必要ありません。 それ以上の洗濯物量の場合(浸け置き後、他の洗濯物といっしょに洗濯する場合も含め)は10ℓのお湯に対して本製品15gから20gを目安としてください。 この場合も、洗濯機での洗濯の際に洗剤の追加は必要ありません。 |
| 使用可能な生地 | 水洗いできる白物、色物 柄物の繊維製品(木綿、麻、化学繊維) |
| 使用不可の生地 | 毛、絹の製品 水洗いできないもの 含金属染料で染めたもの |
ユーザー様のご要望にお応えして
豊富なラインナップをご用意いたしました
350g35回分パック
ご購入はこちら→
350g35回分パック×2個セット
ご購入はこちら→
お徳用1.2kg120回分パック
ご購入はこちら→
お徳用1.2kg120回分パック×3個セット
ご購入はこちら→
お徳用1.2kg120回分パック×6個セット
ご購入はこちら→
お徳用1.2kg120回分パック×10個セット
ご購入はこちら→
まずは「気になる臭いに消臭!ピカイチ」を
試してみたいという方のためにご用意いたしました。
5回分お試しセット
ご購入はこちら→
加齢臭・汗等の臭いをスッキリ落とす。除菌もシッカリの衛生洗剤☆◇メール便にて送料無料◇
レビュー
商品の評価:



-点(0件)
お店の情報
お店の評価:



-点(0件)
連絡・応対
-
配送スピード
-
梱包
-